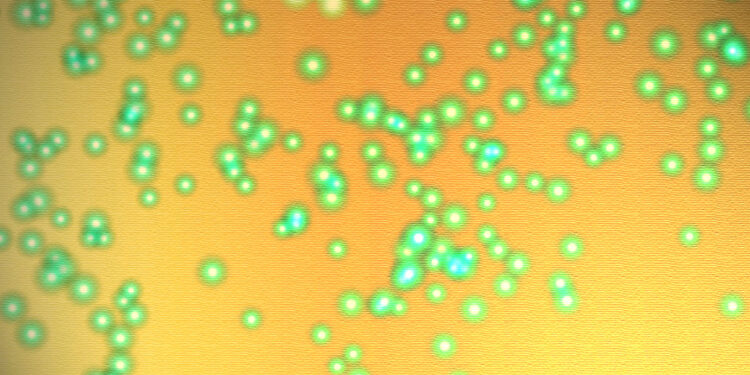
Measles

Measles Disease outbreaks are the result of a highly contagious viral infection that mostly affects the respiratory system. Measles is caused by the measles virus, and outbreaks are most common in communities with low vaccination rates. When an infected individual coughs or sneezes, the virus spreads by respiratory droplets and can live in the air and on surfaces for several hours.
Outbreaks can have devastating effects, particularly for vulnerable groups including as newborns, pregnant women, and individuals with weakened immune systems. Measles complications include pneumonia, encephalitis (brain swelling), and, in severe instances, death.
Measles outbreaks are normally controlled using public health interventions such as vaccination programs, quarantine measures, contact tracing, and public awareness campaigns to educate people about the need of controlling this disease before it gets worst in most situations.

Symptoms and Consequences
Symptoms of measles usually occur 10 to 14 days following exposure to the virus. Initial symptoms include a high fever, cough, runny nose, and red, watery eyes. A few days later, a distinctive rash forms, beginning on the face and extending down the body.
consequences of Measles can cause a variety of consequences, particularly in vulnerable populations such as young children, pregnant women, and those with weaker immune systems. Complications may include pneumonia, ear infections, diarrhea, encephalitis (brain swelling), and, in severe cases, death.
Vaccination is the most effective strategy to avoid measles. The measles vaccination is commonly delivered as part of the measles, mumps, and rubella (MMR) vaccine, which is normally given in two doses.
The first dose is administered between the ages of 12 and 15 months, followed by the second dose between the ages of 4 and 6. Vaccination not only protects people, but it also contributes to herd immunity, which helps to avoid epidemics and protects those who are unable to be immunized.
There is no specific antiviral treatment for measles, thus treatment focuses on symptom management and consequences. This could include rest, fluids, fever-reducing drugs, and antibiotics for subsequent bacterial infections.
Global Impact, Prior to the widespread use of the measles vaccination, measles was the top cause of death in children globally. While immunization efforts have considerably reduced the worldwide measles burden, outbreaks continue, particularly in areas with poor vaccination rates.
The significance of vaccination: maintaining high vaccination rates.
People who have measles usually have a variety of symptoms that vary in intensity. Here’s what happens to those who get measles:
- Incubation Period: After being exposed to the measles virus, symptoms develop 10 to 14 days later. During this time, the virus reproduces in the body.
- Early Symptoms are similar to those of many other respiratory illnesses. They may include high fever, runny nose, cough, and Red, watery eyes (conjunctivitis).

Koplik Spots
Before the rash emerges, little white spots known as Koplik spots may appear inside the mouth, particularly on the inside lining of the cheeks. These are considered a typical early indication of measles.
Measles Rash, A noticeable rash usually occurs a few days after symptoms begin. This rash comprises of flat, red patches that appear on the face and progress down the body over several days. The rash is typically accompanied by a high fever.
problems, While most people recover from measles without major problems, others, particularly small children, pregnant women, and persons with compromised immune systems, may suffer from more severe sickness.
Complications
Pneumonia is a common and sometimes serious consequence, especially in young children. Measles can cause middle ear infections, which can result in hearing loss. Encephalitis is a potentially fatal brain inflammation. Severe dehydration: Particularly in cases with considerable vomiting.
The majority of people with measles recover completely within a few weeks. The rash and other symptoms gradually fade as the immune system eliminates the virus from the body.
Individuals with measles should relax, stay hydrated, and seek medical assistance if they experience severe symptoms or complications. Furthermore, because measles is very contagious, infected people should avoid contact with others to prevent the virus from spreading further, especially during the most contagious time, which is usually from a few days before the rash shows to several days after.
Written By Kyla Hughes
Sources:
NBC News: Measles in the U.K.: Health authorities warn outbreak could grow
ABC News: Measles outbreaks are occurring in some pockets of the US. Here’s why doctors are concerned
CBS News: Data shows at least 8,500 U.S. schools at greater risk of measles outbreaks as vaccination rates decline
Featured Image Courtesy of Valerie Everett‘s Flickr Page – Creative Commons License
First Inset Image Courtesy of Dr. Yale Rosen Atlas of Pulmonary Pathology Flickr page – Creative Commons License